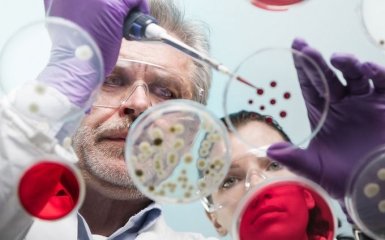
Украинские ученые доказали эффективность стволовых клеток в лечении коронавируса

В Украине впервые провели исследование лечения коронавируса стволовыми клетками. Клеточная терапия оказалась эффективной - мезенхимальные стволовые клетки позволили снизить уровень воспаления даже у тех пациентов, которые переносили ковид в тяжелой форме, с двусторонней пневмонией и сатурацией ниже 93%. Кроме того, что стволовые клетки подавили цитокиновый шторм, уже через неделю после их введения у пациентов начали восстанавливаться пораженные ковидом легкие. Сравнив эти результаты с состоянием пациентов, которые проходили лечение утвержденными МОЗ методами, украинские ученые пришли к выводу, что метод применения стволовых клеток является не только безопасным, но и эффективным - у пациентов не только сокращается период выздоровления, но и снижаются риски развития фиброза легких. Об этом сообщает ONLINE.UA со ссылкой на обнародованные данные Института молекулярной биологии и генетики.
В исследовании лечения коронавируса стволовыми клетками принимали участие 13 пациентов в возрасте 36-73 лет. У всех них ковид протекал в тяжелой форме. Спустя неделю после введения стволовых клеток четыре пациента полностью выздоровели, а через 24 недели компьютерная томография показала, что у 12 респондентов практически восстановились легкие. При этом в контрольной группе пациентов из 15 человек, которые не получали клеточную терапию, один человек умер, а у 7 пациентов появились признаки фиброза легких спустя 8 недель после традиционного лечения.
"Эти данные позволяют утверждать, что на сегодняшний день применение мезенхимальных стволовых клеток является перспективным методом борьбы с фиброзным перерождением ткани легких вследствие пневмонии, вызванной коронавируса SARS-CoV-2", - констатировал старший научный сотрудник Института молекулярной биологии и генетики НАНУ, кандидат биологических наук Владимир Шаблий, который руководит исследованием "Изучение состояния дыхательной, сердечно-сосудистой и иммунной систем у больных с пневмонией COVID-19 после трансплантации криоконсервированных аллогенных мезенхимальных стволовых клеток".
В ИМБГ поясняют, что цель исследования заключается в сравнении эффективности клеточной терапии ковида и лечения коронавируса фармакологическими препаратами, которые утвердил Минздрав. В ходе исследования пациентам трижды ввели по 1 млн мезенхимальных стволовых клеток на 1 кг веса. Клеточные препараты были изготовлены биотехнологической лабораторией Института клеточной терапии в соответствии с международными стандартами. Исследование продолжается, наблюдать за пациентами будут в течение года, после чего ученые смогут получить полноценные данные об эффективности клеточной терапии для лечения коронавируса.
"Мы должны сравнить отдаленные результаты эффективности применения стволовых клеток с методом лечения, утвержденным протоколом Минздраве. Данные наблюдения на двадцать четвертой неделе после введения позволяют сделать вывод, что метод применения стволовых клеток является не только безопасным, не наблюдалось никаких нежелательных явлений, но и эффективным как в скорости выздоровления пациентов, так и в предупреждении развития фиброза легких", - подытожил Шаблий.
Важно отметить, что исследования эффективности стволовых клеток в лечении коронавируса и восстановления поврежденных ковидом легких проводятся во многих странах мира. Ученые и ведущие эксперты в области клеточных биотехнологий уже доказали, что мезенхимальные стволовые клетки имеют свойство эффективно восстанавливать поврежденные ткани и модулировать нужную иммунный ответ организма. Клеточная терапия позволяет эффективно и безопасно лечить многие серьезные заболевания, как сахарный диабет 2 типа, аутоиммунные заболевания, повреждения спинного мозга, аутизм, ДЦП, остеоартроз, рассеянный склероз. Как показывают последние исследования, стволовые клетки также эффективны и в лечении коронавируса.
Ранее ONLINE.UA публиковал результаты исследований лечения стволовыми клетками коронавируса в мире.